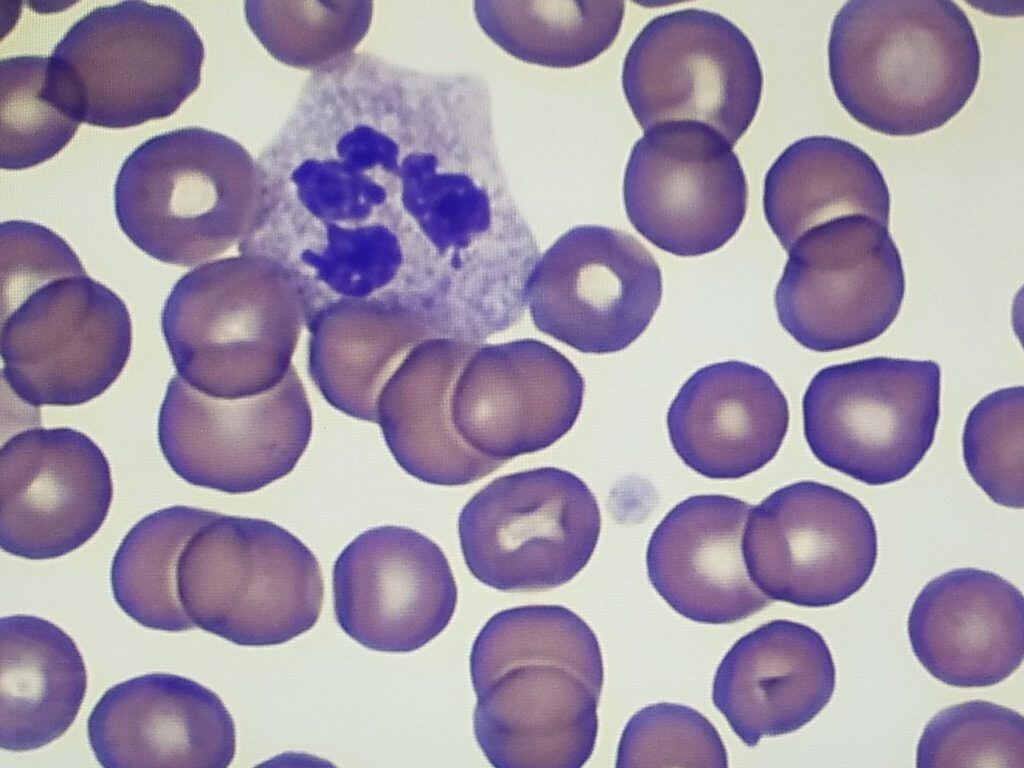

1 min read
How To Set-Up and Conduct a Wright’s Stain
Wright’s, Wright-Giemsa and Giemsa stains follow the same protocol, with the second step being swapped for the preferred stain. The Wright-Giemsa...
Wright’s stain and Wright-Giemsa stain were created to make blood cell morphology more visible. They contain both eosin and methylene blue to better differentiate neutrophils, cytoplasm, and other cell parts within blood and bone marrow specimens. Consistent quality in these stains is essential. If the basophilic or eosinophilic staining is too strong, it can cause issues for pathologists that are accustomed to evaluating specimens with a different stain appearance.
This post covers how to adjust staining protocols for specimens that are “too blue” or “too pink” after using a Wright’s stain or Wright-Giemsa stain.
Adjust basophilic staining that’s too strong or “too blue”
This issue is most commonly observed with classical stains conducted on an automated slide stainer. If you’re seeing nucleus staining that is “too blue”, we have some solutions you can try.
For more suggestions on adjusting your staining techniques to meet your requirements download our eBook, Lab Technician’s Guide to Troubleshooting Common Issues with Biological Stains, call one of our application experts at 800-441-0366 or email info@ethosbiosciences.com. We love to help.

1 min read
Wright’s, Wright-Giemsa and Giemsa stains follow the same protocol, with the second step being swapped for the preferred stain. The Wright-Giemsa...
1 min read
Looking to improve the definition of your Wright’s or Wright-Giemsa stain? We can help! Classical hematology stains are useful for clear...
1 min read
Choosing between Wright’s stains or Wright-Giemsa stains for your hematology specimens is often more a matter of your pathologist’s preference than...